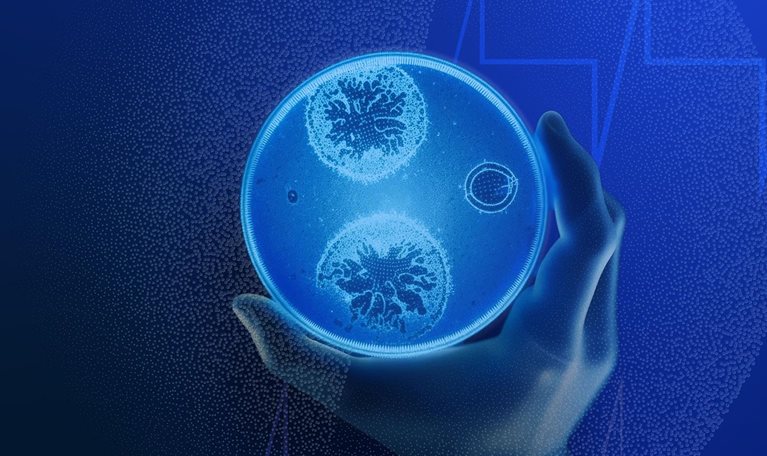
Abstract illustration of a gloved hand holding a glowing petri dish with cells, evoking scientific innovation and future growth in life sciences.

Rob co-leads our life sciences, biopharma, medical products, and health technology spaces globally and is a member of the North America Leadership Team. He assists a broad range of healthcare clients, on topics ranging from pre-IPO venture-backed biotechnology and midsize medical-device companies to large, diversified, multinational healthcare companies. Rob offers support to leadership teams on corporate strategy, mergers, acquisitions, divestitures, portfolio optimization, commercial performance, R&D, and operational improvement.
Rob also focuses on innovating how we serve our healthcare clients—including bringing new capabilities like digital and analytics, performance transformation, and capability building to organizations as well as by providing more flexible support models for a broader range of clients, such as high-growth, earlier-stage healthcare organizations. He is active in McKinsey’s approach to productivity transformation in healthcare as well as the firm’s globalization initiative, having worked extensively on projects internationally, including in Brazil, China, Europe, India, Japan, the Middle East, and Russia.
Before joining McKinsey, Rob was a corporate lawyer focusing on M&A, IPOs, and private-equity-backed transactions.